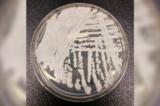

March, 2024
-
1 March
Luật bắt giữ người nhập cư bất hợp pháp của Texas bị thẩm phán liên bang chặn lại
Hôm 29/02, một thẩm phán liên bang đã tạm thời chặn một đạo luật của Texas vốn cho phép cảnh sát tiểu bang bắt giữ những người vượt biên trái phép.
-
28 February
Ngũ Giác Đài miễn tội cho ông Lloyd Austin về hành vi sai trái khi giữ kín việc nhập viện
Ngũ Giác Đài đã công bố một báo cáo về việc nhập viện của Bộ trưởng Quốc Phòng Lloyd Austin và lý do vì sao ông đã chậm trễ trong việc thông báo việc nhập viện của mình cho Quốc hội và Tòa Bạch Ốc.
-
26 February
AT&T hoàn tiền cho khách hàng sau khi mạng lưới bị gián đoạn
AT&T cho biết họ sẽ hoàn tiền cho khách hàng vì đợt gián đoạn mạng lưới kéo dài 12 giờ hôm 22/02 trên khắp Hoa Kỳ, khiến một số người thậm chí không thể gọi 911.
-
24 February
Điều tra viên tư nhân của ông Trump: Dữ liệu điện thoại mới gây nghi ngờ nghiêm trọng về mối quan hệ của bà Fani Willis
Theo một hồ sơ tòa án, một điều tra viên tư nhân thu thập các cuộc gọi giữa Biện lý Quận Fulton Fani Willis và công tố viên đặc biệt của bà, phát hiện ra rằng họ đã thực hiện hơn 2,000 cuộc gọi và 12,000 tin nhắn vào năm 2021.
-
20 February
Người đứng đầu WHO cảnh báo về ‘Bệnh X,’ thúc đẩy hiệp ước đại dịch
Người đứng đầu Tổ chức Y tế Thế giới (WHO) lại đưa ra một cảnh báo về cái gọi là đại dịch “Bệnh X”, nói rằng đó là “vấn đề khi nào, chứ không phải nếu như.”
-
20 February
Các nhà phân tích pháp lý: Phán quyết sắp tới của Tối cao Pháp viện có thể ảnh hưởng đến ông Jack Smith
Ý kiến của một số nhà phân tích pháp lý về quyết định sắp tới của Tối cao Pháp viện trong vụ án mà Biện lý Đặc biệt Jack Smith đưa ra để chống lại cựu Tổng thống Donald Trump.
-
20 February
CDC xác nhận đợt bùng phát ‘không xác định’ trên du thuyền đã lan rộng
CDC cho biết một 154 người trên thuyền du thuyền Queen Victoria bị nhiễm bệnh ‘không xác định’ với triệu chứng chính là tiêu chảy và nôn mửa.
-
19 February
Quan chức IRS cảnh báo người Mỹ về các thông báo thu nợ sắp tới
Sở Thuế vụ (IRS) xác nhận rằng họ hiện đang gửi thông báo thu nợ tới người Mỹ sau hai năm tạm dừng, trong khi các quan chức cảnh báo rằng những người nhận được những bức thư đó không nên bỏ qua chúng.
-
16 February
Bà Fani Willis tuyên bố bà ‘chưa bao giờ’ nói với ai ở nơi làm việc về mối quan hệ tình cảm của mình
Biện lý quận Futon đã tỏ thái độ tức giận trong phiên điều trần hôm thứ Năm khi luật sư luật sư bào chữa, Ashleigh Merchant, đề cập tới mối quan hệ của bà và công tố viên hàng đầu trong vụ truy tố ông Trump.
-
16 February
FBI cảnh báo về những mối đe dọa bầu cử ‘vô cùng đáng báo động’
Các quan chức FBI đưa ra lời cảnh báo về những nguy cơ “đáng báo động” mà cuộc bầu cử tháng Mười Một sắp tới sẽ đối mặt như là dữ liệu cử tri bị tấn công và những cuộc gọi được thực hiện bằng AI.
-
11 February
Ban hành cảnh báo sau khi các nhà nghiên cứu liên kết nước tăng lực với ý định tự tử ở trẻ em
Các nhà nghiên cứu Anh cho biết nước tăng lực có thể gây nguy hiểm cho não của trẻ.
-
8 February
Các quan chức cho biết đợt bùng phát bệnh nhiễm nấm chết người đầu tiên đã được xác nhận ở tiểu bang Washington
Các quan chức cho biết đợt bùng phát bệnh nhiễm nấm chết người đầu tiên đã được xác nhận ở tiểu bang Washington
-
6 February
Cung điện Buckingham loan báo Vua Charles được chẩn đoán mắc bệnh ung thư
Trong một tuyên bố hôm 05/02, Cung điện Buckingham cho biết Vua Charles III được chẩn đoán mắc một dạng ung thư và đã bắt đầu điều trị.
-
6 February
Cơ quan liên bang của Hoa Kỳ ban hành cảnh báo lỗ hổng bảo mật cho các thiết bị Apple
Tuần trước (29/01-04/02), một cơ quan liên bang của Hoa Kỳ đã gửi cảnh báo về một lỗ hổng ảnh hưởng đến iPhone, iPad, Macbook, và các thiết bị khác của Apple, nói rằng lỗ hổng này có thể dẫn đến các vi phạm an ninh nghiêm trọng.
-
5 February
Văn phòng đổng lý tiểu bang California xác nhận sai sót về phiếu bầu năm 2024
Theo một tuyên bố vào tuần trước (29/01-04/02), văn phòng đổng lý tiểu bang California đã thừa nhận một sai sót dẫn đến việc một ứng cử viên Thượng viện Hoa Kỳ “không có bảng giới thiệu thông tin bỏ phiếu” cho cuộc bầu cử sơ bộ ngày 05/03 và cho hướng…
-
3 February
Hoa Kỳ: Thẩm phán hoãn xét xử vụ kiện ông Trump can thiệp vào bầu cử liên bang
Ngày xét xử vụ kiện cựu Tổng thống Donald Trump can thiệp bầu cử đã bị hoãn lại, thẩm phán liên bang đảm trách vụ kiện này xác nhận hôm thứ Sáu (02/02).
-
3 February
CDC ban hành ‘Cảnh báo sức khỏe’ về các ca bệnh sởi trên khắp Hoa Kỳ
CDC ban hành 'Cảnh báo sức khỏe' về các ca bệnh sởi trên khắp Hoa KỳLink bài liên quan:
-
31 January
UPS thông báo cắt giảm 12,000 việc làm do khối lượng kiện hàng giảm
Hôm 30/01, United Parcel Service (UPS) đã thông báo cắt giảm 12,000 việc làm sau khi báo cáo sự sụt giảm về số lượng kiện hàng được vận chuyển, vài tháng sau khi công ty đạt được thỏa thuận với Teamsters để trả lương cao hơn cho tài xế.
-
31 January
Ngoại trưởng Blinken cảnh báo: Đây là ‘thời điểm nguy hiểm nhất ở Trung Đông’
Ngoại trưởng Antony Blinken cảnh báo rằng cuộc xung đột đang diễn ra ở Trung Đông dường như là giai đoạn ‘nguy hiểm nhất’ của khu vực này trong khoảng 50 năm qua.
-
29 January
Chính sách cắt giảm thuế từ thời ông Trump sắp hết hạn: Đây là các mức thuế mà quý vị sẽ phải trả
Các khoản giảm thuế được thông qua vài năm trước dưới thời chính phủ cựu Tổng thống Trump sẽ hết hạn trong vòng hai năm tới.
-
29 January
Ngũ Giác Đài loan báo những quân nhân Hoa Kỳ đầu tiên thiệt mạng kể từ khi cuộc chiến ở Gaza bắt đầu
Chính phủ Tổng thống Biden cho biết rằng ba quân nhân Mỹ đã thiệt mạng vào sáng sớm hôm 28/01 trong một cuộc tấn công bằng phi cơ không người lái vào một căn cứ nhỏ của Hoa Kỳ ở Jordan.
-
27 January
Quan chức CDC: Biến thể COVID mới có vẻ không nghiêm trọng hơn
Biến thể JN.1 COVID-19 chịu trách nhiệm cho phần lớn các trường hợp gần đây ở Hoa Kỳ có thể không nghiêm trọng hơn.
-
25 January
Chủ tịch Đảng Cộng Hòa Arizona từ chức sau cáo buộc hối lộ bà Kari Lake
Chủ tịch Đảng Cộng Hòa Arizona Jeff DeWit cho biết ông đã từ chức hôm thứ Tư (24/01) sau khi một đoạn ghi âm của ông bị rò rỉ cho thấy dường như ông đã đề nghị tiền bạc cho ứng cử viên Kari Lake để bà rút khỏi cuộc đua vào Thượng viện.
-
22 January
Tin chính thức: Ông Trump sẽ có tên trên phiếu bầu sơ bộ năm 2024 ở Connecticut
Bất chấp việc một số tiểu bang đưa ra quyết định loại tên ông Trump ra khỏi lá phiếu bầu sơ bộ, Đổng lý tiểu bang Connecticut đã chính thức đưa ra quyết định để tên ông Trump trên lá phiếu sơ bộ của tiểu bang này.
-
22 January
Các quan chức y tế cảnh báo nguy cơ phơi nhiễm sởi tại 2 phi trường lớn
Các quan chức y tế cảnh báo nguy cơ phơi nhiễm sởi tại 2 phi trường lớn ở khu vực Hoa Thịnh Đốn